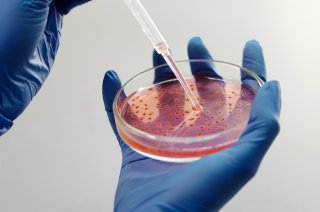

category_news
Minimising your administrative burden: EU registered collections
As a user of genetic resources, it can be difficult to gather information on the ABS conditions that apply when accessing and using genetic resources. When using material from a collection registered under the EU ABS Regulation, you can minimise the administrative burden while still complying with ABS rules.
The European Commission keeps a list of collections registered under Article 5 of the EU ABS Regulation (Regulation (EU) 511/2014): the EU Register of Collections. These collections apply standardised procedures for supplying genetic resources and related information. The procedures ensure that, along with the genetic resource, all relevant ABS information is provided to third parties and with documentation providing evidence that the genetic resources and the related information were accessed in accordance with applicable ABS legislation or regulatory requirements and, where relevant, under mutually agreed terms (MAT).
Obtaining genetic resources from a registered collection makes it easier for users to comply with ABS legislation. If you have obtained a genetic resource from a collection included in the EU Register of Collections you are considered to have exercised your due diligence obligations with regards to collecting information (the information listed in Article 4(3) of the Regulation). However, you may still need to submit a due diligence declaration. More information on due diligence declarations: ‘To DECLARE or not to DECLARE: when to submit a due diligence declaration’.
Be aware that when the intended use changes, there might be a need to seek new or updated prior informed consent (PIC) from the provider country and establish MAT for the new use, if it is not covered by the PIC and MAT obtained and relied upon by the registered collection.
Where to find the EU Register of Collections
The EU Register of Collections is available on the ABS webpage of the European Commission under the heading ‘Register of collections’. It currently includes collections from the Leibniz-Institut DSMZ, the French Collection for Plant-associated Bacteria (CIRM-CFBP) and the Pierre Fabre Research Institute.
More information on the registered collections and how to obtain their genetic resources is found on the European Commission’s website under Register of Collections.
